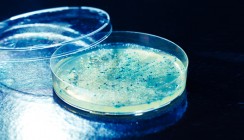

Wissenschaft und Forschung 20.02.2014
Fukushima: Kinderzähne dokumentieren Strahlenbelastung
Drei Jahre nach der Reaktorkatastrophe von Fukushima sollen nun Wissenschaftler die Strahlenbelastung von damals, und damit das Risiko für die Anwohner, anhand von Kinderzähnen nachweisen. Mütter von Kindern, die damals in der Region wohnten, sind aufgerufen, herausgefallene oder gezogene Zähne ihrer Kinder zur Verfügung zu stellen.
Man hofft auf 4.000 Zahnspenden jährlich. In den Milchzähnen, die im Wachstum noch nicht so fest wie bei Erwachsenen sind, lassen sich Rückstände der radioaktiven Strahlung aufspüren.
Neben einer wissenschaftlichen Gesamtauswertung soll auch jeder Spender individuell über die Resultate informiert werden. Bis eine Auswertung vorgestellt wird, werden allerdings noch mehrere Jahre ins Land gehen.
Während die verheerenden Folgen noch weit über die Region hinaus zu spüren sind, versucht Japans Ministerpräsident Shinzo Abe erneut, wieder Kraftwerke in Betrieb zu nehmen.
Quelle: Spreadnews